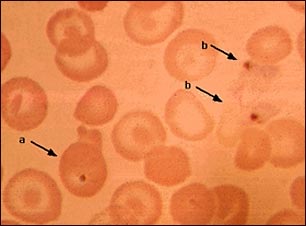
Malaria, fotomicrograf&iacute;a de par&aacute;sitos celulares

![]() | ![]() | ![]() |
Malaria, fotomicrografía de parásitos celulares
La malaria es una enfermedad causada por parásitos. Esta fotografía muestra parásitos de malaria teñidos de color naranja oscuro presentes (a) en el interior de los glóbulos rojos, y (b) fuera de las células. Se pueden ver unas grandes células que tienen la apariencia de blancos, células cuya relación con la enfermedad se desconoce
Actualizado: 8/10/2008
